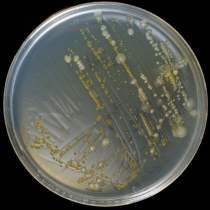

Flavobakterios hos fisk
Flavobacterium psychrophilum orsakar sjukdom och dödlighet hos laxfisk och andra fiskarter världen över. Framförallt drabbas regnbågsyngel där bakterien orsakar hög dödlighet, vilket gett sjukdomen det engelska namnet ”rainbow trout fry syndrome”.
Även större fisk drabbas, ofta då med fenskador och sår på kroppen. Sjukdomen uppträder vanligen vid vattentemperaturer under 15° C, varför sjukdomen även kallas ”Bacterial coldwater disease”.
Förekomst
Symtom

Etiologi och patogenes
Infektionsagens:
Infektionen orsakas av den gramnegativa bakterien Flavobacterium psychrophilum, tidigare även känd som bland annat Flexibacter psychrophilus och Cytophaga psychrophila. Bakterien bildar gulfärgade kolonier på de speciella agarplattor som krävs för att bakterien ska växa fram. Studier visar att bakteriens uppsättning av proteolytiska enzymer, som verkar nedbrytande på fiskens vävnader, påverkar bakteriens sjukdomsframkallande förmåga (virulens). Det förekommer alltså både mer och mindre virulenta stammar av F. psychrophilum.
Infektionsport:
Infektionsporten är inte fullständigt klarlagd. Gälar, hud och/eller via mage-tarm är möjliga infektionsvägar. Upptag i fisken underlättas om fiskens normala skyddsbarriärer är påverkade, som till exempel vid hudskador eller vid störningar i fiskens naturliga slemproduktion.
Spridning i djuret:
F. psychrophilum orsakar lokala skador på grund av sina proteolytiska enzymer, som bryter ned fenor och annan vävnad. Bakterien kan sprida sig till blodbanorna och därmed transporteras till fiskens inre organ.
Smittvägar:
Smittan kan överföras från infekterad fisk eller infekterat vatten, så kallad horisontell smittöverföring. Smittan kan även överföras från fisk som är bärare av bakterien utan att visa tecken på sjukdom. Man misstänker att smittan kan överföras till ynglen via föräldrafisken då F. psychrophilum påvisats i sperma, ovarievätska och utvändigt på romkornen. Det finns även studier som indikerar att bakterien kan förekomma inuti romkornen, så kallad vertikal smittöverföring.
Överlevnad:
F. psychrophilum kan överleva upp till 300 dygn i färskvatten. Bakterien kan också överleva skyddad i biofilmer i fisktråg eller annan utrustning.
Provtagning och diagnostik
Diagnos ställs efter odling av vävnadsprover på särskilt framtaget agarmedium. Bakterien växer inte på blodagar. Framväxta gula kolonier (bild 2) identifieras med masspektrometri (MALDI-TOF) eller med molekylärgenetiska tekniker, till exempel PCR. Utväxta kolonier undersöks alltid avseende känsligheten för antibiotika genom en resistensundersökning.
Behandling och profylax
God skötsel och god hygien med bortplockning av sjuk och död fisk är de viktigaste åtgärderna för att minska smittrycket och reducera dödligheten. Behandling av yngel med kloramin eller saltbad kan ge ett förebyggande skydd och reducera mängden externt förekommande bakterier. Vid konstaterad diagnos och efter resistensundersökning kan antibiotikabehandling sättas in. Under senare år har kommersiella vacciner som kan ge ett visst skydd mot F. psychrophilum tagits fram.
Senast granskad 2023-09-14